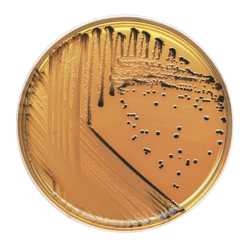
Salmonella Shigella Agar Plat

Search Criteria
Products meeting the search criteria
Brand: SISCO
Model: SISCO
Product Details Sabouraud Chloramphenicol Agar Concentration 65.00 gm/lit.
Part D
Storage : 8 to 25°C (Cool & dry area)
Shelf Life : 36 Months
HSN Code : 38210000
IMDG Identification :Not Regulated for Transport (Non-Haz)Specifications
Appearance (Colour) Light yellow
Appearan..
460.92 SAR
Ex Tax:400.80 SAR
Brand: Techno
Model: Techno
For the selective cultivation and isolation of yeasts and molds..
7.48 SAR
Ex Tax:6.50 SAR..
475.41 SAR
Ex Tax:413.40 SAR
Brand: SISCO
Model: SISCO
Product OverviewSabouraud Dextrose Agar28055Concentration 65.00 gm/lit.
Part D
Storage : 8 to 25°C (Cool & dry area)
Shelf Life : 36 Months
HSN Code : 38210000
IMDG Identification :Not Regulated for Transport (Non-Haz)Package Size: 500 G..
260.00 SAR
Ex Tax:260.00 SAR
Brand: Scharlab
Model: Scharlab
Sabouraud agar or Sabouraud dextrose agar (SDA) is a type of agar growth medium containing peptones...
486.62 SAR
Ex Tax:423.15 SAR
Brand: HiMedia
Product Overview Sabouraud Dextrose Agar,500Gfor cultivation of yeasts, moulds and aciduric microorganisms...
517.50 SAR
Ex Tax:450.00 SAR
Model: MilliporeSigma
..
1,794.00 SAR
Ex Tax:1,560.00 SAR..
281.06 SAR
Ex Tax:244.40 SAR..
5.00 SAR
Ex Tax:5.00 SAR
Brand: SISCO
Product Overview 59437Simmons Citrate Agar(Citrate Agar)
Concentration 24.28 gm/lit.
Part D
Storage: 8 to 25°C (Cool & dry area)
HSN Code: 38210000
IMDG Identification: Not Regulated for Transport (Non-Haz)Package Size: 100 G ..
92.00 SAR 92.00 SAR
Ex Tax:80.00 SAR..
425.50 SAR
Ex Tax:370.00 SAR..
3,072.23 SAR
Ex Tax:2,671.50 SAR
Brand: SISCO
Model: SISCO
Product Overview39930
SS Agar (Salmonella Shigella Agar)Concentration 60.02 gm/lit.
Part D
Storage : 8 to 25°C (Cool & dry area)
Shelf Life : 36 Months
HSN Code : 38210000
IMDG Identification :Not Regulated for Transport (Non-Haz)Package Size: 500 g..
500.83 SAR
Ex Tax:435.50 SAR
Model: 1056
..
384.00 SAR
Ex Tax:384.00 SAR
Model: 50165/500
Product Details TCBS Agar (B/S)(Thiosulfate Citrate Bile Salts Sucrose Agar)
Concentration 89.08 gm/lit.
Part D
Storage : 8 to 25°C (Cool & dry area)
Shelf Life : 36 Months
HSN Code : 38210000
IMDG Identification :Not Regulated for Transport (Non-Haz)
Specifications
Composition :
P..
454.78 SAR
Ex Tax:395.46 SAR